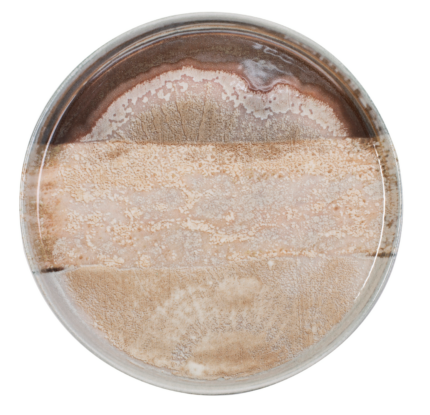

ΠΙΑΤΟ ΒΑΘΥ NATURA SUN 27 CM BYBONE
Τα πιάτα της ByBone παράγονται aπό πορσελάνη
με προδιαγραφές υψηλής ποιότητας με αλουμίνα . Η αλουμίνα είναι γνωστή για την υψηλή σκληρότητά της και την αντοχή της στη φθορά. Όταν προστίθεται στην πορσελάνη, καθιστά το υλικό πιο ανθεκτικό και λιγότερο ευαίσθητο σε χτυπήματα, ρωγμές ή φθορά. Λόγω της ανθεκτικοτητας τους, είναι κατάλληλα για χρήση σε εστιατόρια, ξενοδοχεία και άλλους επαγγελματικούς χώρους.Ψήνονται σε υψηλή θερμοκρασία για μεγαλύτερη
αντοχή και το ντεκόρ τοποθετείται μέσα
στην υάλωση (in-glazed) και δεν ξεθωριάζει.Με εργοστασιακή εγγύηση εφ‘ όρου ζωής στο τσιπάρισμα του χείλους.